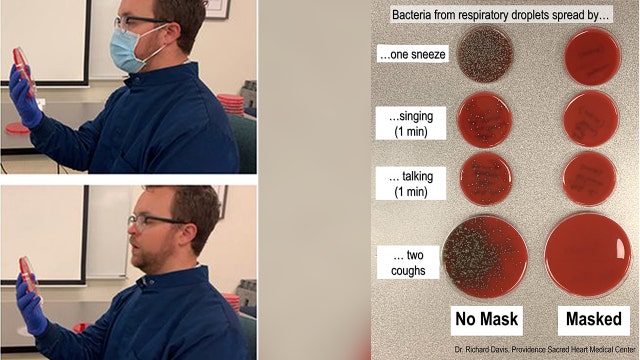
Doctor demonstrates how face mask blocks respiratory droplets from spreading

Multiple airlines stop serving alcohol, food on planes in response to COVID-19 pandemic
Several airlines announced their new measures as part of an effort to maintain passenger safety.
Several airlines announced their new measures as part of an effort to maintain passenger safety.
Doctor demonstrates how face mask blocks respiratory droplets from spreading
One medical expert’s widely-shared Twitter thread demonstrates the effectiveness of wearing a facial covering amid a pandemic that is far from over.
One medical expert’s widely-shared Twitter thread demonstrates the effectiveness of wearing a facial covering amid a pandemic that is far from over.
Murphy bans drinking, eating at Atlantic City casinos; Borgata delays reopening
Gamblers coming back to Atlantic City casinos this week will find a different world: no smoking, drinking or eating inside.
Gamblers coming back to Atlantic City casinos this week will find a different world: no smoking, drinking or eating inside.
AT&T waives internet overage charges through September 30 as COVID-19 cases surge in US
AT&T has announced it will waive internet overage fees through Sept. 30 as COVID-19 cases in the U.S. see a significant uptick, with several states rolling back their reopening plans.
AT&T has announced it will waive internet overage fees through Sept. 30 as COVID-19 cases in the U.S. see a significant uptick, with several states rolling back their reopening plans.
Puerto Rico to demand COVID-19 test results from arriving passengers
Puerto Rico's governor on Tuesday announced strict new rules for all passengers flying into Puerto Rico in a bid to curb coronavirus cases as officials blame recent outbreaks on those who flew to the U.S. territory and were infected.
Puerto Rico's governor on Tuesday announced strict new rules for all passengers flying into Puerto Rico in a bid to curb coronavirus cases as officials blame recent outbreaks on those who flew to the U.S. territory and were infected.
Cuomo sending State Police, monitors to NYC ahead of indoor dining decision
Gov. Andrew Cuomo said in a Tuesday television interview that he plans to send state police and health and liquor officials to New York City Tuesday night ahead of his decision expected Wednesday on indoor dining.
Gov. Andrew Cuomo said in a Tuesday television interview that he plans to send state police and health and liquor officials to New York City Tuesday night ahead of his decision expected Wednesday on indoor dining.
Spirit Halloween squashes closure rumors, says it will return despite COVID-19 pandemic
Despite rumors circulating that the franchise would not be returning until 2021, Spirit Halloween has announced that it will be back this year.
Despite rumors circulating that the franchise would not be returning until 2021, Spirit Halloween has announced that it will be back this year.
Florida school district to spend $4 million on installing transparent screens in classrooms
A north Florida school district has voted to install transparent screens in classrooms in response to the coronavirus pandemic.
A north Florida school district has voted to install transparent screens in classrooms in response to the coronavirus pandemic.
Stadium executive beats COVID-19
From his living room, inside his home in West Orange, New Jersey, Bill Squires, 66, describes what life is like back at home, after beating COVID-19.
From his living room, inside his home in West Orange, New Jersey, Bill Squires, 66, describes what life is like back at home, after beating COVID-19.
NY, NJ, CT restrict access to travelers from 16 states due to fear of coronavirus spread
A mandatory quarantine of 14 days has been extended to travelers entering New York, New Jersey and Connecticut to 16 from the 8 states listed when the advisory was first issued last week.
A mandatory quarantine of 14 days has been extended to travelers entering New York, New Jersey and Connecticut to 16 from the 8 states listed when the advisory was first issued last week.
EU reopens its borders to 14 countries but not to US tourists
The European Union announced Tuesday that it will reopen its borders to travelers from 14 countries, but most Americans have been refused entry for at least another two weeks due to soaring coronavirus infections in the U.S.
The European Union announced Tuesday that it will reopen its borders to travelers from 14 countries, but most Americans have been refused entry for at least another two weeks due to soaring coronavirus infections in the U.S.
Judge rules Cuomo's eviction suspension is constitutional
New York Gov. Andrew Cuomo acted constitutionally by temporarily banning evictions because of the coronavirus, a judge ruled Monday.
New York Gov. Andrew Cuomo acted constitutionally by temporarily banning evictions because of the coronavirus, a judge ruled Monday.
How risky is flying during the coronavirus pandemic?
Flying can increase your risk of exposure to infection, but airlines are taking precautions and you can too.
Flying can increase your risk of exposure to infection, but airlines are taking precautions and you can too.
Tie-dye designers build their home businesses amid a pandemic
Tie-dye is certainly not a new trend but it is one a lot of people seem to be embracing all over again.
Tie-dye is certainly not a new trend but it is one a lot of people seem to be embracing all over again.
More than 200 Planet Fitness gym-goers asked to quarantine after 1 tests positive for COVID-19
Members who visited the Planet Fitness location in Morgantown, West Virginia are being asked to quarantine for at least two weeks.
Members who visited the Planet Fitness location in Morgantown, West Virginia are being asked to quarantine for at least two weeks.
Cuomo may slow down Phase 3 reopening in New York City due to 'complications'
A planned Phase Three reopening in New York City expected to occur on July 6 could be slowed, announced Gov. Andrew Cuomo.
A planned Phase Three reopening in New York City expected to occur on July 6 could be slowed, announced Gov. Andrew Cuomo.
Broadway theaters to remain dark until January
The shutdown on Broadway has been extended again — until at least early January. Although an exact date for performances to resume has yet to be determined, Broadway producers are now offering refunds and exchanges for tickets purchased for shows through Jan. 3.
The shutdown on Broadway has been extended again — until at least early January. Although an exact date for performances to resume has yet to be determined, Broadway producers are now offering refunds and exchanges for tickets purchased for shows through Jan. 3.
Cuomo to Trump: Tell Americans to wear face masks
NY Gov. Andrew Cuomo called on President Donald Trump Monday to sign an executive order requiring all people to wear face coverings as the number of COVID-19 cases has increased across the country.
NY Gov. Andrew Cuomo called on President Donald Trump Monday to sign an executive order requiring all people to wear face coverings as the number of COVID-19 cases has increased across the country.
'The worst is yet to come': Coronavirus pandemic 'not even close to being over,' WHO official warns
June 30 marks six months since the World Health Organization was first notified of the coronavirus pandemic.
June 30 marks six months since the World Health Organization was first notified of the coronavirus pandemic.
Indoor shopping malls reopen in New Jersey
New Jersey's indoor shopping malls reopened on Monday from their COVID-19 pause.
New Jersey's indoor shopping malls reopened on Monday from their COVID-19 pause.